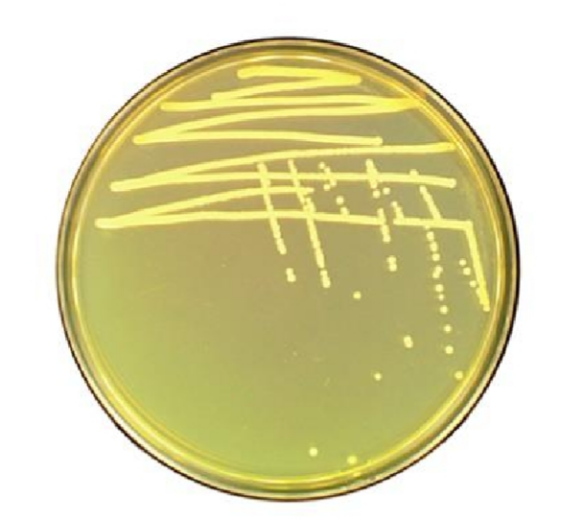
b7b139da-bb7e-4798-aa9e-92a42cb4ee01

1.杀鲑气单胞菌(Aeromonas salmonicida)
物种名:杀鲑气单胞菌
拉丁学名:Aeromonas salmonicida
分类学地位:细菌界Bacteria;变形菌门Proteobacteria;
γ-变形菌纲Gammaproteobacteria;气单胞菌目Aeromonadales;
气单胞菌科Aeromonadaceae;气单胞菌属Aeromonas
杀鲑气单胞菌(Aeromonas salmonicida)于1894年首次被Emmerich等学者分离得到,是已知最古老的鱼类疖病的病原体,可感染多种淡海水养殖和野生鱼类,给水产养殖业带来严重的经济损失。目前,被大多数学者所承认的所属杀鲑气单胞菌的亚种有杀鲑亚种、杀日本鲑亚种、史氏亚种、溶果胶亚种、无色亚种五个亚种[1]。
1.1生物学特性
1.1.1培养特征
在TSA培养基上25℃培养72 h,会生长白色的菌落,其中有的亚种会产生水溶性褐色素如杀鲑亚种,而其他亚种没有色素产生。如果在TSA平板中加入100 mg/L的考马斯亮兰,则生长的菌落为深蓝色[2]。无色亚种在LB培养基上生长较缓慢,早期菌落稍隆起,白色,质地较硬[3]。杀鲑亚种在脱纤维羊血平板上生长速度较快,28℃培养24 h后,能观察到灰白色、细小、圆形、湿润、边缘光滑的菌落,菌落大小约为0.5 mm[4]。
图1 杀鲑气单胞菌在LB琼脂平板上的菌落形态[5]
1.1.2形态学特征
杀鲑气单胞菌属革兰阴性短杆菌,菌体直径1.3-2.0 μm,无鞭毛,属嗜冷无动力气单胞菌。杀鲑气单胞菌最适生长温度为22-25℃[6],但不能在37℃下生长[7]。无色亚种为单个或成对分布,菌体较小,有荚膜,无芽孢;杀鲑亚种两端钝圆,散在或个别成双排列,无芽孢,大小多在(0.4-1.0) μm×(1.0-2.0) μm,是杆状(多为短杆状或球状)细菌,偶可见有个别长丝状菌丝[3]。

图2 杀鲑气单胞菌显微照片
A:杀鲑气单胞菌革兰氏染色镜检照片[8],B:杀鲑气单胞菌扫描电镜照片[5]
1.1.3生化特征
杀鲑气单胞菌各亚种的生化特性如下表所示[2]。
表1 杀鲑气单胞菌各亚种的生化特性表
| 特性 | 无色亚种 | 杀日本鲑亚种 | 杀鲑亚种 | 史氏亚种 | |
|---|---|---|---|---|---|
| 产生吲哚 | + | + | – | – | |
| 甲基红试验(M.R) | + | + | + | – | |
| V-P反应 | – | + | – | – | |
| 柠檬酸盐 | – | – | – | – | |
| 硫化氢(H2S产生) | – | + | – | + | |
| 水解尿素 | – | – | – | – | |
| 产酸 | 阿东醇 | – | – | – | ? |
| 阿拉伯糖 | – | + | + | ? | |
| 阿拉伯醇 | – | – | – | ? | |
| 纤维二糖 | – | – | – | – | |
| 卫矛醇 | – | – | – | ? | |
| 赤藓醇 | – | – | – | ? | |
| 半乳糖 | + | + | + | – | |
| 甘油 | d | D | d | (-) | |
| 间-肌醇 | – | – | – | – | |
| 乳糖 | – | – | – | – | |
| 麦芽糖 | + | + | + | – | |
| D-甘露醇 | – | + | + | – | |
| D-甘露糖 | + | + | + | ? | |
| 棉籽糖 | – | – | – | – | |
| L-鼠李糖 | – | – | – | ? | |
| D-山梨醇 | – | – | – | (-) | |
| 海藻糖 | + | + | + | – | |
| D-木糖 | – | – | – | – | |
| 黏液酸 | – | – | – | – | |
| 苯丙氨酸脱氢酶 | – | – | – | – | |
| 精氨酸双水解酶 | + | + | + | (-) | |
| 鸟氨酸脱羧酶 | – | – | – | – | |
| 明胶水解 | + | + | + | + | |
| 氰化钾(KCN)生长 | – | – | – | ? | |
| 丙二酸利用 | – | – | – | ? | |
| D-葡萄糖产酸 | + | + | + | (+) | |
| D-葡萄糖产气 | – | + | + | (+) | |
| 七叶灵水解 | – | + | + | – | |
| 酒石酸 | – | – | – | ? | |
| 脂酶(玉米油) | + | + | + | – | |
| DNase | + | + | + | + | |
| 硝酸盐还原 | + | + | + | ? | |
| 氧化酶 | + | + | + | + | |
| ONPG | d | D | d | + | |
| 柠檬酸 | – | – | – | ? | |
| 棕色可溶性色素 | – | – | + | – | |
1.2分布、传播与致病性
1.2.1分布与传播
该菌主要感染鲑科鱼类等脊椎动物,可从养殖水体、鱼类肠道及相关栖息地中分离得到。传播以水为主要媒介,污染水体通过养殖用水等扩散,患病与健康鱼类直接接触也可传播,病原体可经皮肤损伤等途径侵入宿主[9]。
1.2.2致病性
杀鲑气单胞菌的致病作用与其携带的多种毒力因子密切相关,其中一些毒力因子能够较大的影响杀鲑气单胞菌菌株的致病性,包括Ⅲ型分泌系统、外毒素、胞外产物、铁载体、群体感应和S层蛋白。Ⅲ型分泌系统的基因主要以毒力岛的形式分布在pAsa5质粒上,包含编码结构蛋白、调节蛋白和效应蛋白在内的36个基因。其中已有多种效应蛋白(AexT、AopH、AopO、Ati2、AopN、ExsE和AopP)被证明存在于杀鲑气单胞菌中。杀鲑气单胞菌在缺失Ⅲ型分泌系统后无法正常侵染鱼体,也无法抵抗阿米巴原虫的捕食。外毒素(如气溶素、溶血素、肠毒素)通过分泌至宿主环境造成组织损伤,临床菌株中已证实其基因广泛存在。因此,外毒素很可能参与杀鲑气单胞菌的毒力机制。
杀鲑气单胞菌的胞外产物发挥关键破坏作用:蛋白酶和脂肪酶降解宿主结构蛋白;甘油磷脂-胆固醇酰基转移酶(GCAT)水解细胞膜磷脂导致溶血,且能与AspA蛋白酶或脂多糖结合增强毒性;A膜蛋白则提升细菌疏水性,促进自凝集以逃避宿主免疫攻击。为满足铁需求,细菌分泌铁载体(主要为Acinetobactin和Amonabactin),在宿主体内低铁条件下高效摄取铁元素,此能力可以作为细菌毒力的标志之一。群体感应(QS)系统通过信号分子(如AsaI)感知菌群密度,调控毒力基因的表达从而调节微生物生物功能,缺失该系统的菌株毒力显著减弱。此外,具有S层蛋白的杀鲑气单胞菌毒株能够进入宿主巨噬细胞并在其内存活,在杀鲑气单胞菌的致病性上发挥着不可替代的作用。
杀鲑气单胞菌可经皮肤、鳃、口及血液等多种途径传染,导致鱼类发生疖疮
病或溃疡病。被杀鲑气单胞菌感染的鱼类,经常出现部分器官发黑甚至严重出血或溃烂。大量病理学相关文献和实验表明,患病鱼中杀鲑气单胞菌菌体主要集中在鱼的肌肉和免疫器官,特别是在鱼的脾脏、肾脏和肝脏组织[6]。
1.3检测方法
(1)传统方法:据国家标准(GB/T 15805.6-2008)规定,细菌分离和生化鉴定的方法检测杀鲑气单胞菌[2]。主要步骤包括:从鱼体患病处取样并进行显微镜观察,随后接种到大豆酪蛋白琼脂培养基(TSA)上,25℃培养72 h,对菌落进行染色观察、运动性观察、氧化酶实验以及最后进行生化鉴定并需要对亚种的生化特性进行对照确定其具体亚种类型。这种分离方法相对来说较为复杂、费时耗力且依赖于专业人员和实验室设备。
(2)分子生物学方法:刘帅[10]等人基于杀鲑气单胞菌毒力阵列蛋白基因(vapA)的保守序列,设计特异性引物建立了SYBR Green I实时荧光定量PCR检测方法。该方法通过引物AsV-F/AsV-R对vapA基因进行扩增,仅对杀鲑气单胞菌及其亚种呈现阳性反应,与其他细菌无交叉反应,特异性良好。构建的标准曲线线性关系显著(y=-4.8345x+42.535,R²=0.998),最低检测限达34 copies/μL,灵敏度较常规PCR提高1000倍。
表2 杀鲑气单胞菌vapA基因实时荧光定量PCR引物序列
| 名称 | 序列 |
| AsV-F | 5′-CGTCCGAGACAGGTATCAGC-3′ |
| AsV-R | 5′-TCCAAGGTGAAGGCCAATT-3′ |
1.4典型案例
2021年3月江苏常熟市某养殖场河川沙塘鳢出现大规模死亡现象,发病水温为12-15℃,其主要症状为体表不同程度的溃疡,并且鳍条充血、出血。研究从濒死的河川沙塘鳢分离到优势生长细菌,经理化特性和分子特征确定其为杀鲑气单胞菌[11]。
1.5防治对策
在抗生素使用上,国内防控该菌引发的疾病常借助氯霉素、四环素等抗生素,然而多数菌株已产生多重耐药性,所以防治过程中需增强药物使用的针对性,精准把控用量,防止因盲目、广泛使用而引发耐药性;疫苗制备也是有效的防治手段,商业性疫苗作用于北极红点鲑时,发现可通过抗体介导补体生成、细胞毒介导免疫等途径发挥作用;此外,β-葡聚糖作为非淀粉多糖,能增强鱼类免疫功能、提升免疫力,可作为饲料添加剂调节胃肠道微生物群;将特定益生菌添入饲料喂养,也能在一定程度上防止感染[6]。
参考文献
[1] Susana, Merino, Juan M. The Aeromonas salmonicida Lipopolysaccharide Core from Different Subspecies: The Unusual subsp.pectinolytica. Frontiers in microbiology, 2016, 7: 125.
[3] 樊景凤, 明红霞, 王斌 等. 中国近海病原生物. 北京: 海洋出版社, 2019.
[4] 周冬仁, 罗毅志, 杭小英 等. 1株乌鳢源杀鲑气单胞菌杀鲑亚种的分离与鉴定. 海洋湖沼通报, 2015: 64-70.
[5] 王佳佳. ZupT与ZnuABC调控嗜温性杀鲑气单胞菌SRW-OG1毒力的分子机制研究. 集美大学, 2023.
[6] 刘智鹏. 杀鲑气单胞菌的筛选及其细胞毒素的鉴定. 湖南师范大学, 2020.
[7] Austin B, Austin D A. Bacterial Fish Pathogens: Disease of Farmed and Wild Fish. Springer: Cham, 2016.
[8] JIN S, FU S, LI R et al. Identification and histopathological and pathogenicity analysis of Aeromonas salmonicida salmonicida from goldfish (Carassius auratus) in North China. Aquaculture and Fisheries, 2020, 5: 36-41.
[9] Janda J M, Abbott S L. The genus Aeromonas: taxonomy, pathogenicity, and infection. Clinical microbiology reviews, 2010, 23: 35-73.
[10] 刘帅, 王荻, 卢彤岩 等. 实时荧光定量PCR扩增特异性vapA基因检测杀鲑气单胞菌. 水产学报, 2017, 41: 1928-1935.
[11] 李杰, 刘国兴, 钱且奇 等. 河川沙塘鳢病原杀鲑气单胞菌致病性及感染后宿主免疫相关基因差异表达分析. 淡水渔业, 2024, 54: 45-56.
.png)
